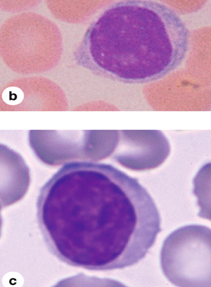

Components of plasma
largely water with inorganic salts and plasma proteins (albumins and globulins and fibrinogen)
3 classes of blood cells
RBCs WBCs, leukocytes platelets (thrombcytes)
which type of blood cell houses hemoglobin
RBC
what are reticulocytes?
immature red blood cells. they stil have some ribodomes and organelles and stain differently.
the 5 types of leukocytes can be broken down into 2 categories:
1) granulocytes: neutrophils, eosinophils, and basophils (have polymorphic nuclei) 2) agranulocytes: lymphocytes and monocytes.
how do leukocytes leave the blood?
by squeezing between endothelial cells of capillaries and veins to function in tissues.
most numerous leukocyte. Function
neutrophil. Defense against bacterial infections by phagocytosis
granulocytes are produced in the ___
bone marrow.
what type of cell is this?

Neutrophils. In blood smears neutrophils can be identified by their multilobulated nuclei, with lobules held together by thin strands.
what kind of nucleus does an eosinophil have? functioN?
BILOBED nucleus, but hard to see.
Function:
What type of leukocyte is this?

Eosinophils. Eosinophils are about the same size as neutrophils but have bilobed nuclei and abundant coarse cytoplasmic granules.
least common WBC. Function?
Basophil. Has large basophilic granules of histamine and heparin, involved in allergic reactions.
Cell type?

Basophil. Rarest WBC
second most common leukocyte. Function?
lymphocyte. Large nucleus with pale rim of cytoplsms. Are involved in immunological defense against invading microorganisms, antigens, and cancer cells
3 types of lymphocytes
1) B cells: differentiate into antibody-seecreting plasma cells. Help with HUMORAL IMMUNE RESPONSE
2) T cells: has antigen receptors in their membranes. Can execute a cell-mediated immune response/cytotoxic T cell response.
3) Null ells; can kill foreign or infected cells without an antigen-antibody interaction (natural killer cells).
cell type?
. Lymphocytes. Lymphocytes are agranulocytes and lack the specific granules characteristic of granulocytes.
Which are the largest WBCs? Function?
Monocytes. Large and horseshoe shaped nucleus. AGRANULAR
Cell type?

. Monocytes. Monocytes are large agranulocytes with diameters from 12 to 20 µm that circulate as precursors to macrophages
Platelets are aka ____. What do they arise from?
aka THROMBOCYTES.
•Are irregular-shaped cell fragments (NOT CELLS THEMSELVES) that arise from a megakaryocyte in bone marrow
Megakaryoblasts undergo _____ and differentiate into megakaryocytes
endomitosis: DNA replication without cell division. Megakaryoblast have one big nucleus. Megakaryocytes has a nucleus inside that consists of SEVERAL LOBES.
Cell type?

a) megakaryoblast
b/c) megakaryocyte
Where can you find a megakaryocyte?
bone marrow
Find the platelet producing cell

megakaryocyte. there’s two in the pic.
Ultrastructurally, a platelet typically shows a system of ____ and ____ _____ near the periphery to help maintain its shape
Ultrastructurally a platelet typically shows a system of microtubules and actin filaments near the periphery to help maintain its shape